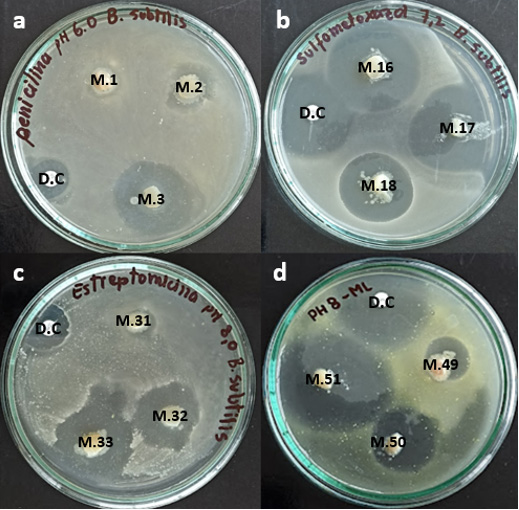

Revista Veterinaria. 2026; 37(1)
https://doi.org/10.30972/vet.3719099
Artículo Original




11Laboratorio de Microbiología de Alimentos, Facultad de Ciencias Biológicas.
22Laboratorio de Bromatología y Nutrición, Universidad Nacional de San Cristóbal de Huamanga (UNSCH).
33Universidad Nacional Autónoma de Huanta, Ayacucho Perú.
44Departamento Académico de Lenguas y Literatura, Facultad de Ciencias de la Educación.
55Laboratorio de Biología Celular y Molecular - UNSCH, Portal Independencia 57, Ayacucho, 05003, Perú.
Recibido: 01 octubre 2025 / Aceptado: 22 diciembre 2025
Resumen
El consumo de carne de pollo representa una de las principales fuentes de proteína animal en el Perú. Sin embargo, el uso intensivo de antibióticos en la producción avícola genera residuos farmacológicos en los tejidos musculares, que representa un riesgo para la inocuidad alimentaria y la salud pública. El presente estudio tuvo como objetivo detectar residuos de antibióticos en carne de pollo comercializada en los mercados de Ayacucho durante el año 2025. Se recolectaron 70 muestras provenientes de tres mercados locales, las cuales fueron analizadas utilizando el método microbiológico de difusión en placa con Bacillus subtilis ATCC 6633 y Micrococcus luteus ATCC 9341. Los resultados indicaron que el 18,6% de las muestras fueron positivas, presentando una mayor frecuencia de residuos de Sulfametoxazol (38,5%) y Eritromicina (30,8%), seguidos por Penicilina y Estreptomicina, ambos con un 15,4%. Se concluye que existe un riesgo potencial para los consumidores. La detección frecuente de residuos de sulfametoxazol y eritromicina en carne de pollo peruana indica un riesgo sanitario global significativo, que demanda una vigilancia sanitaria rigurosa y la implementación de controles efectivos. Por consiguiente, es fundamental fortalecer la vigilancia sanitaria y asegurar la calidad de la carne de pollo, con el fin de mitigar la resistencia antimicrobiana y salvaguardar la inocuidad alimentaria tanto en Perú como a nivel global.
Palabras clave: residuos de antibióticos, carne de pollo, resistencia antimicrobiana, salud pública.
Abstract. Chicken meat is one of the primary sources of animal protein in Peru. However, the intensive use of antibiotics in poultry production can result in pharmacological residues in muscle tissues, posing risks to food safety and public health. This study aimed to detect antibiotic residues in chicken meat sold in markets in the city of Ayacucho, Peru, during 2025. A total of 70 samples were collected from three local markets and analyzed using the microbiological agar diffusion method with Bacillus subtilis ATCC 6633 and Micrococcus luteus ATCC 9341 as indicator organisms. Antibiotic residues were detected in 18.6% of the samples, with sulfamethoxazole (38.5%) and erythromycin (30.8%) being the most frequently identified compounds, followed by penicillin and streptomycin (15.4% each). These findings indicate a potential risk to consumers. The frequent detection of sulfamethoxazole and erythromycin residues in chicken meat highlights the need for strengthened health surveillance and effective regulatory controls to reduce the risk of antimicrobial resistance and ensure food safety at both national and global levels.
Key words: antibiotic residues, chicken meat, antimicrobial resistance, public health.
Durante la última década, la carne de pollo es considerada como la principal fuente de proteína animal en el ámbito global, atribuible a su accesibilidad económica, eficiencia en los sistemas de producción y su elevado perfil nutricional (Fei et al. 2022). No obstante, la intensificación de la producción avícola permitió el uso frecuente de antibióticos como promotores de crecimiento, agentes profilácticos o tratamientos terapéuticos. Esta práctica es especialmente prevalente en países de ingresos bajos y medianos, donde la regulación y el control del uso antimicrobiano aún enfrentan desafíos significativos (Huong-Anh et al. 2020, Founou et al. 2021).
El uso descontrolado de fármacos en la producción animal, junto con el incumplimiento de los períodos de retiro establecidos, conduce a la acumulación de residuos farmacológicos en los tejidos musculares. Esta situación constituye un riesgo para la inocuidad de los alimentos y representa una amenaza significativa para la salud pública (Kumar et al. 2020). Estos compuestos, incluso en concentraciones inferiores a los límites máximos de residuos, pueden inducir reacciones alérgicas, alterar la microbiota intestinal y, sobre todo, favorecer el desarrollo de resistencia antimicrobiana, un fenómeno que la Organización Mundial de la Salud (OMS) ha identificado como una de las principales crisis sanitarias globales actuales (OMS 2023).
La evidencia científica reciente confirma la magnitud y el alcance global del problema en la producción avícola. En India, Chandrakar et al. (2023) detectaron residuos de antibióticos en el 43,7% de las muestras de carne de pollo analizadas, de las cuales el 17,8% superó los límites máximos de residuos (LMR) establecidos. En Egipto, Kamouh et al. (2024) identifican la presencia de oxitetraciclina, gentamicina y ciprofloxacina en más del 20% de las muestras evaluadas. De manera similar, en China, Fei et al. (2022) reportaron que el 20,47% de las muestras de carne de pollo contenían residuos de antibióticos, predominando las tetraciclinas y las quinolonas. En Kenia, Ngigi y Odundo (2023) encontraron concentraciones de sulfonamidas y β-lactámicos por encima de los niveles permitidos, lo que representa un riesgo particularmente elevado para la población infantil debido a su menor masa corporal. En conjunto, estos hallazgos evidencian que la presencia de residuos de antibióticos en productos avícolas constituye un problema de salud pública mundial, que trasciende tanto las fronteras geográficas como los niveles de desarrollo económico (Celis et al. 2023).
La evaluación local de los residuos de antibióticos en los alimentos y el ambiente es crucial para proteger la salud de los consumidores y sustentar políticas regulatorias eficaces. Este enfoque es relevante en el marco de One Health, que reconoce la interdependencia la salud humana, animal y ambiental, además, enfatiza la necesidad de estrategias integradas para gestionar los riesgos asociados al uso de antimicrobianos. En este contexto, los residuos de antibióticos en la cadena alimentaria constituyen un riesgo directo para la salud pública y favorecen al creciente problema de la resistencia a los antimicrobianos, que exige vigilancia local y acción coordinada (Serna et al. 2022, Silva et al. 2025).
En el Perú, diversos estudios han confirmado la presencia de residuos de antibióticos en carne de pollo en regiones como Lima, Piura y Tacna, evidenciando el incumplimiento de los límites máximos de residuos (LMR) establecidos por el Codex Alimentarius (Azañero y Chiroque 2010, Gómez Laureano 2013). No obstante, la información disponible es limitada en Ayacucho, a pesar del acelerado crecimiento del sector avícola regional (Dirección Regional Agraria-Ayacucho 2023). Por tal motivo, el presente estudio tuvo como objetivo detectar residuos de antibióticos en carne de pollo comercializada en los mercados de Ayacucho durante el año 2025.
Diseño experimental y recolección de muestras. Se realizó un estudio observacional, transversal y descriptivo con el objetivo de detectar residuos de antibióticos en carne de pollo comercializada en los principales mercados de la ciudad de Ayacucho, Perú, durante el periodo comprendido entre enero y marzo de 2025. La metodología incluyó la recolección aleatoria de muestras representativas, seguida de análisis microbiológicos cualitativos para la detección preliminar de actividad antimicrobiana en los tejidos evaluados.
La investigación se desarrolló en tres mercados representativos: Nery García Zárate, Carlos F. Vivanco y 12 de abril, seleccionados por su relevancia en el abastecimiento local y representatividad dentro de la cadena de comercialización avícola. Para la recolección de datos, se aplicó el método microbiológico de difusión en cuatro placas (Four Plate Test, FPT), descrito por Ramos et al. (2003), como técnica de tamizaje adaptada para la detección de residuos antibióticos. El tipo de muestreo fue censal obteniéndose un total de 70 muestras de músculo pectoral, con un peso aproximado de 250 g cada una. La toma de muestras se efectuó bajo condiciones habituales de comercialización y utilizando utensilios estériles y guantes desechables para evitar contaminación cruzada. Posteriormente, las muestras fueron colocadas en bolsas de polietileno estériles, etiquetadas y transportadas en contenedores isotérmicos a una temperatura de 4 °C ± 1 °C hasta el laboratorio, donde se almacenaron a −18 °C ± 1 °C hasta su análisis, garantizando así la integridad y confiabilidad de los resultados obtenidos.
Detección microbiológica. La detección cualitativa de residuos se realizó mediante el método microbiológico de difusión en cuatro placas (Four Plate Test, FPT), recomendado por la Unión Europea para cribado de antimicrobianos en alimentos de origen animal (Pérez 2005, Espitia-Díaz 2016). Se emplearon dos cepas bacterianas indicadoras: Bacillus subtilis ATCC 6633, sensible a penicilinas, tetraciclinas, sulfonamidas y aminoglucósidos, cultivada en agar antibiótico N°11 (Liofilchem®, lote 610315, Italia) ajustado a pH 6,0 y 0,1; 7,2 y 0,1 y 8,0 y 0,1. Micrococcus luteus ATCC 9341, sensible a macrólidos, cultivado en agar ajustado a pH 8,0 ± 0,1.
Preparación Agar Tripticasa Soja (TSA) en pico de flauta. Se pesaron 20 g de agar TSA y se disolvieron en 500 mL de agua destilada estéril contenida en un matraz Erlenmeyer de 1.000 mL. La mezcla se calentó hasta ebullición bajo agitación constante. Posteriormente, una vez enfriada a 45 °C, el pH se ajustó a 7,3 ± 0,2 (medido a 25 °C) mediante la adición de HCl 1N o NaOH 1N, utilizando un potenciómetro digital (HI98130, Hanna Instruments). La solución se distribuyó en tubos de ensayo de 10 mL y se sometió a esterilización en autoclave a 121 ± 1 °C y 15 psi durante 15 minutos. Finalmente, los tubos se inclinaron a un ángulo de 30° ± 1° para permitir la solidificación del medio.
Preparación de agar antibiótico N° 11. Se pesaron con precisión 15,25 g de agar Antibiótico N°11 y se disolvieron en 500 mL de agua destilada estéril en un matraz Erlenmeyer de 1.000 mL. La solución homogénea se calentó hasta ebullición bajo agitación constante. Posteriormente, se distribuyó en cuatro matraces Erlenmeyer de 250 mL, con alícuotas de 125 mL cada una, para el ajuste individual del pH. Las dos primeras alícuotas se ajustaron a pH 8,0, la tercera a pH 6,0 ± 0,1 y la cuarta a pH 7,2, mediante la adición de HCl 1 N o NaOH 1 N, según fuera necesario. Las mediciones de pH se realizaron con un potenciómetro digital (HI98130, Hanna Instruments), cuya exactitud es de ± 0,01 unidades de pH. Finalmente, los medios se esterilizaron en autoclave a 121 ± 1 °C y 15 psi durante 15 minutos y se almacenaron a 4 °C hasta su utilización
Preparación y estandarización de inóculos bacterianos. Se realizó un cultivo primario de B. subtilis ATCC 6633 y M. luteus ATCC 9341 mediante siembra por estría en tubos con agar tripticaseína-soja (TSA) en posición inclinada (“pico de flauta”), incubados a 37 ± 1 °C durante 24 h. Los cultivos se conservaron como existencias en refrigeración (2-8 °C), con repiques mensuales para garantizar su viabilidad. Para la estandarización de los inóculos, se prepararon suspensiones bacterianas en 10 mL de solución salina estéril (0,85 % NaCl), ajustando la turbidez mediante comparación visual con los patrones de la escala de McFarland (0,5; 1,0 y 2,0). Cada suspensión se sembró por extensión en placas de Petri conteniendo agar TSA (1 mL por placa) y se incubó a 37 °C durante 24 h. La concentración bacteriana (UFC mL-1) se calculó mediante recuento en placa. La suspensión correspondiente a la escala 0,5 de McFarland fue seleccionada para los ensayos posteriores, ya que proporcionó un crecimiento óptimo para ambas cepas, con una concentración promedio de (1,5 ± 0,2) × 10⁸ UFC mL-1.
Preparación de muestras de tejido muscular y siembra por la técnica de difusión en 4 placas. Se extrajeron trozos de tejido muscular (8 mm de diámetro × 20 mm de longitud) de pechugas de pollo refrigeradas, utilizando un sacabocado estéril. Cada trozo se seccionó con bisturí estéril para obtener discos de 2 mm de espesor. Se empleó agar Antibiótico N.º 11, ajustado a distintos valores de pH según el antimicrobiano evaluado: pH 6,0 para penicilina; pH 7,2 para sulfametoxazol; y pH 8,0 para estreptomicina y eritromicina. Los medios de cultivo, previamente templados a 45 ± 1 °C, se inocularon con 2 mL de suspensiones bacterianas estandarizadas de B. subtilis ATCC 6633 y M. luteus ATCC 9341 (equivalentes a la escala 0,5 de McFarland). Posteriormente, se vertieron 11 mL de la mezcla en placas de Petri, obteniendo una capa uniforme de aproximadamente 2 mm de espesor.
Una vez solidificado el agar, se colocaron tres discos de tejido muscular por placa, separados entre sí por una distancia mínima de 1,5 cm. Como controles positivos, se incluyen discos impregnados con concentraciones estándar de antibióticos: 0,01 UI de penicilina, y concentraciones equivalentes de sulfametoxazol, estreptomicina y eritromicina. Todas las placas se incubaron en atmósfera aeróbica a 37 ± 0,5 °C durante 24 h. El ensayo se realizó por triplicado para garantizar la reproducibilidad y minimizar el ciclo experimental.
Lectura de resultados y Análisis estadístico. Los halos de inhibición se midieron mediante un calibrador vernier. Se consideró muestra positiva aquella que presentó un halo de inhibición ≥ 2 mm; muestra sospechosa, aquella con un halo de 1-2 mm, y muestra negativa, cuando el diámetro fue < 1 mm o no se observó zona de inhibición (González-Aguilar et al. (2022). Se demostró positiva la presencia de residuos de antibióticos cuando se observó un halo de inhibición ≥ 2 mm. Todos los ensayos se realizaron por triplicado para minimizar el ciclo experimental.
Los resultados se codificaron en una base de datos y se analizaron utilizando el software estadístico SPSS versión 27.0 (IBM Corp., Armonk, NY, EE.UU.). Se aplicó estadística descriptiva para determinar la frecuencia absoluta y relativa de residuos de antibióticos, tanto por el mercado como por tipo de compuesto antimicrobiano. Además, se empleó la prueba de chi-cuadrado (χ²) para comparar proporciones y evaluar si existían diferencias estadísticamente significativas en la distribución de residuos entre los mercados estudiados, con un nivel de significancia del 5% (p<0,05).
Asimismo, la muestra para la presente investigación estuvo compuesta por 70 establecimientos que comercializan carne de pollo en los mercados de Huamanga. De estos, el 54,3% correspondió al mercado Nery García Zárate, el 20,0% al mercado Carlos F. Vivanco y el 25,7% al mercado 12 de Abril (Tabla 1).

Los resultados obtenidos en la Figura 2 mostraron que 18,6% de los establecimientos se encontró evidencia que la carne contenía antibiótico y en 81,4% de los establecimientos no se encontró presencia de residuos de antibióticos en la carne que expenden en los mercados estudiados.

En las muestras positivas analizadas donde se detectó la presencia de antibióticos, los hallazgos se distribuirán de la siguiente manera según el mercado de origen (Figura 3). En el mercado Nery García Zárate, el 15,4% de las muestras de carne presentaron sulfametoxazol y un porcentaje idéntico (15,4%) contenía eritromicina. Además, se identificó penicilina en el 7,7% de las muestras y estreptomicina en otro 7,7%. En el mercado Carlos F. Vivanco, el 15,4% de las muestras fue positivo para sulfametoxazol, mientras que el 7,7% mostró presencia de eritromicina y otro 7,7% de estreptomicina. Por su parte, en el mercado 12 de Abril, el 7,7% de las muestras contenían penicilina, y porcentajes equivalentes (7,7% cada uno) fueron positivos para sulfametoxazol y eritromicina, respectivamente.

De las 13 muestras positivas con residuos antibióticos, un 15,4% contenían Penicilina, otro 15,4% tenían Estreptomicina, un 38,5% contenían Sulfametoxazol y un 30,8% de las muestras de carne contenían Eritromicina, como indica la Figura 4.

La mayoría de los establecimientos con residuos antibióticos correspondieron al mercado Nery García Zárate, seguido por Carlos F. Vivanco y 12 de Abril.

El presente estudio reveló que el 18,6% de las muestras de músculo pectoral de pollo comercializadas en los mercados de Ayacucho resultaron positivas para residuos de antibióticos. Este porcentaje se encuentra dentro del rango reportado en estudios previos en países en desarrollo, que varía entre el 10% y el 45% (Kumar et al. 2020, Chandrakar et al. 2023). Los resultados confirman que la presencia de residuos antibióticos en la cadena alimentaria avícola es un problema persistente a nivel global, incluyendo mercados locales peruanos.
La detección cualitativa mediante el método de las cuatro placas es un procedimiento de cribado ampliamente validado y recomendado para la vigilancia rutinaria de residuos antibióticos (Espitia-Díaz 2016). La presencia de halos de inhibición iguales o mayores a 2 mm indica que las concentraciones de antibióticos en el tejido muscular son suficientes para ejercer actividad biológica, representando un riesgo potencial para la salud del consumidor y constituyendo un factor de presión selectiva para el desarrollo de resistencia antimicrobiana (RAM) (OMS 2023).
Respecto a la distribución por mercados, aunque no se observaron diferencias estadísticamente significativas (p>0,05) en la proporción de muestras positivas entre el mercado Nery García Zárate (15,8%), Carlos F. Vivanco (28,6%) y 12 de Abril (16,7%), la variabilidad observada podría atribuirse a diferencias en las fuentes de abastecimiento, prácticas de manejo posproducción o al cumplimiento variable de los periodos de retiro por parte de los proveedores en cada centro de venta. Estos hallazgos sugieren que el problema no es homogéneo y que los esfuerzos de vigilancia deben ser descentralizados y adaptados a las características específicas de cada mercado.
El perfil de antibióticos detectados en las muestras fue heterogéneo, con predominancia de sulfametoxazol, una sulfonamida, presente en el 38,5% de las muestras positivas, seguida por eritromicina, un macrólido, en el 30,8%. En menor proporción se detectaron penicilina y estreptomicina, ambas en un 15,4%. Este patrón es consistente con reportes internacionales: Kamouh et al. (2024) en Egipto reportaron alta prevalencia de sulfonamidas, mientras que Chandrakar et al. (2023) en India identificaron tetraciclinas y fluoroquinolonas como los antimicrobianos más comunes. La predominancia de sulfametoxazol y eritromicina en nuestro estudio resulta especialmente preocupante. Las sulfonamidas, por su bajo costo y amplio espectro, son ampliamente usadas, pero su uso prolongado ha sido asociado con la rápida selección de genes de resistencia (sul1, sul2 y sul3), frecuentemente hospedados en plásmidos transferibles, que facilita la diseminación de la resistencia antimicrobiana (Ngigi y Odundo 2023). Por otro lado, los macrólidos como la eritromicina son esenciales en medicina humana para tratar infecciones causadas por Campylobacter spp. y Streptococcus pneumoniae; la presencia de residuos de este antimicrobiano en alimentos favorece la selección de mecanismos de resistencia, tales como la metilación del ARN ribosomal 23S (genes erm) y bombas de expulsión (genes mef), comprometiendo la efectividad de tratamientos críticos (Founou et al. 2021).
La presencia simultánea de múltiples clases de antibióticos en la cadena alimentaria, aunque en este estudio no se analizó la multirresistencia bacteriana, sugiere un escenario propicio para la co-selección de determinantes de resistencia. Por ejemplo, los genes de resistencia a aminoglucósidos (como aac y aph) y betalactámicos (como blaTEM) suelen encontrarse asociados en los mismos elementos genéticos móviles, como plásmidos y transposones. Esto implica que la presión selectiva ejercida por un antibiótico, como la estreptomicina, puede favorecer la persistencia y diseminación de resistencia a otros antimicrobianos, como la penicilina (Kumar et al. 2020). Este fenómeno contribuye a la complejidad del problema de la resistencia antimicrobiana y subraya la necesidad de abordajes integrales en su vigilancia y control.
Aunque el porcentaje total de muestras positivas (18,6%) fue inferior al reportado en algunos estudios previos en Perú, como el de Azañero y Chiroque (2010) en Lima, esta aparente mejora debe interpretarse con cautela. Nuestro estudio fue de carácter cualitativo y no cuantificó las concentraciones de residuos para compararlas con los Límites Máximos de Residuos (LMR) establecidos por el Codex Alimentarius o la Administración de Alimentos y Medicamentos (FDA). Es plausible que algunas muestras negativas en la prueba cualitativa contuvieran residuos en concentraciones inferiores al límite de detección del método, pero superiores a los LMR, situación frecuente documentada por Fei et al. (2022). Por lo tanto, estos hallazgos subrayan la necesidad imperiosa de complementar el cribado microbiológico con técnicas cuantitativas confirmatorias, como la cromatografía líquida acoplada a espectrometría de masas (HPLC-MS/MS), en futuras investigaciones para garantizar una evaluación más precisa y rigurosa de la exposición a residuos antibióticos en la cadena alimentaria.
Este estudio se limitó a la detección cualitativa de residuos con actividad antimicrobiana. No se identificaron ni cuantificaron los compuestos específicos, ni se investigó la presencia de bacterias resistentes asociadas a las muestras. Se recomienda que futuros trabajos integren análisis químicos cuantitativos y caracterización molecular de genes de resistencia para una evaluación más comprehensiva del riesgo.
Los resultados obtenidos evidencian una presencia significativa e inaceptable de residuos antibióticos en la carne de pollo comercializada en Ayacucho, con un perfil farmacológico dominado por sulfametoxazol y eritromicina, antimicrobianos relacionados con mecanismos de resistencia que representan un alto impacto para la salud pública. Aunque el método empleado no permite una cuantificación exacta, la detección de actividad antimicrobiana en el 18,6% de las muestras sugiere incumplimientos respecto a los límites máximos de residuos establecidos por normas internacionales y nacionales, que estipulan la ausencia de actividad antimicrobiana detectable para garantizar la inocuidad. Estos hallazgos sugieren una posible falta de control en el uso de antimicrobianos y el incumplimiento de los periodos de retiro en etapas clave de la cadena productiva. Por ello, es urgente fortalecer los sistemas regionales de vigilancia sanitaria bajo el enfoque "Una Salud", integrando la monitorización en animales, humanos y medio ambiente, y promoviendo el uso responsable de antibióticos junto con la implementación de buenas prácticas pecuarias para mitigar el creciente problema de salud pública.
Agradecimiento. A los semilleros de investigación BIOGEN del Laboratorio de Biología Celular y Molecular de la Facultad de Ciencias Biológicas de la Universidad Nacional de San Cristóbal de Huamanga, Ayacucho.
Contribución de los autores. Conceptualización, VAA y GPR: metodología, EEG y ELPÑ: software, NEDE y EGG: validación, VAA: análisis formal, GPR y EGG: investigación, EEG y VAA: recursos, VAA y ELP: redacción: preparación del borrador original, EEG y GPR: redacción: revisión y edición, GPR y YBGC: visualización, YBGC: supervisión, VAA y GPR: administración del proyecto, GPR y VAA: adquisición de financiación, GPR y VAA.
Declaración de conflictos de intereses. Los autores declaran no tener conflictos de intereses financieros ni relaciones personales conocidas que pudieran haber influido en el trabajo presentado en este artículo.
Disponibilidad de datos. Los datos estarán disponibles previa solicitud.